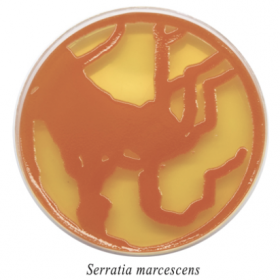
Агар Хоттингера 200 мл

Агар Хоттингера 200 мл
Агар Хоттингера готовый к применению 200 мл
Питательная среда для культивирования различных микроорганизмов: энтеробактерии, сртептококки, псевдомонады.
Данный продукт предназначен для исследовательских целей.
Срок годности 1 год.
- Стерильность: +
- Форма выпуска: Раствор
- Упаковка: 200 мл
- Документы: Для исследовательских целей